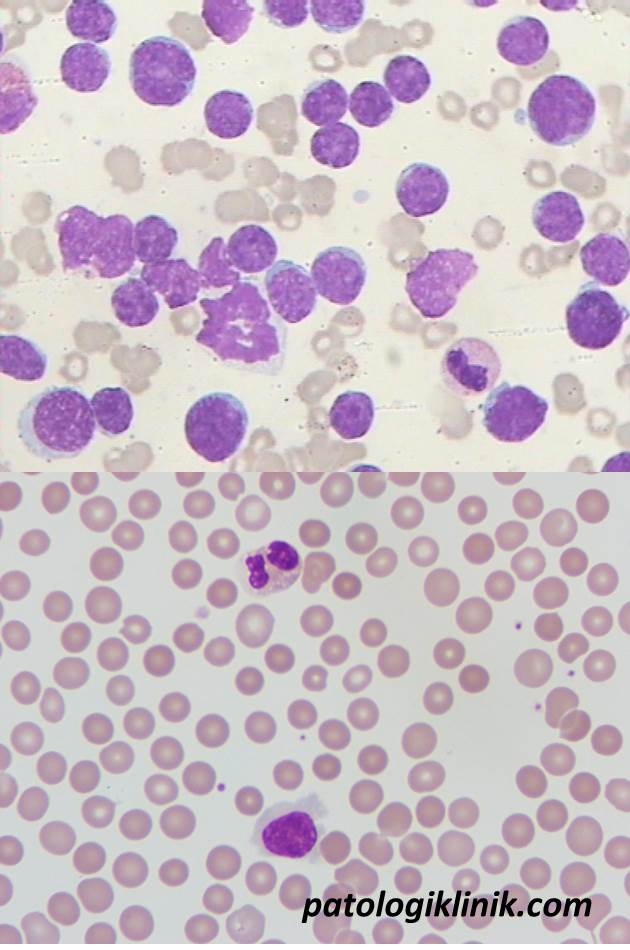
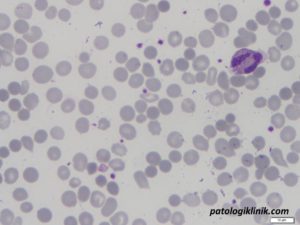

Indikasi Evaluasi Apusan Darah Tepi

Evaluasi apusan darah tepi (EADT) adalah satu pemeriksaan hematologi dasar yang penting untuk penapisan, diagnosis, dan pemantauan perjalanan penyakit dan respon terapi. EADT memiliki nilai yang sangat besar untuk diagnosis berbagai penyakit darah baik primer maupun sekunder karena penyakit lain. Walaupun merupakan pemeriksaan manual, peran EADT masih belum bisa digantikan oleh pesatnya perkembangan teknologi pemeriksaan hematologi secara otomatisasi dan teknik biomolekuler.
Sebagian besar pemeriksaan EADT adalah karena adanya permintaan dari dokter yang menangani pasien (indikasi klinis) dan sebagian kecil diminta sendiri oleh laboratorium (indikasi laboratoris). Laboratorium dapat langsung mengerjakan EADT berdasar adanya temuan abnormal dari pemeriksaan darah lengkap sebagai konfirmasi.
Berikut indikasi pemeriksaan EADT:
Indikasi klinis
- investigasi temuan sitosis (peningkatan sel darah) atau sitopenia (penurunan sel darah)
- diagnosis dan pemantauan penyakit
- gejala klinis mengarah pada anemia, netropenia, atau trombositopenia yang belum jelas penyebabnya
- splenomegali, limfadenopati, atau gejala sistemik yang mengarah pada kelainan hematologi
- kecurigaan infeksi yang dapat didiagnosis dari EADT
- kecurigaan kelainan morfologi sel darah merah, seperti penyakit sel sabit, talasemia
- adanya gangguan fungsi organ terutama pada anak
- ikterus yang tidak diketahui penyebabnya atau ada kecurigaan hemolitik
- limfositosis atau monositosis
- keganasan dengan kecurigaan metastasis ke sumsum tulang
- hiperleukositosis dengan kecurigaan ke arah leukemia

Indikasi laboratoris:
- konfirmasi kelainan kuantitatif yang ditemukan pada hasil DL, atau terdapat perbedaan yang besar antara hasil saat ini dengan hasil sebelumnya
- menindaklanjuti tanda peringatan dari alat hematologi otomatis, seperti: blast, immature granulocyte, platelet clump, NRBC, dll
- melakukan hitung jenis leukosit jika ada tanda peringatan populasi abnormal atau alat tidak bisa membaca hitung jenis karena adanya sel muda



Semoga bermanfaat
Sumber:
- Adewoyin AS and Nwogoh B. Peripheral Blood Film – A Review. Ann Ib Postgrad Med. 2014 Dec; 12(2): 71–79
- Pokja Hematologi PDS Patklin. Panduan Evaluasi dan Standarisasi Pelaporan Sediaan Apus Darah Tepi. 2018




![[Download] Pedoman Nasional Pelayanan Kedokteran Tata Laksana Thalassemia (KMK)](/content/images/uploads/2022/10/KMK.jpg)
![[Download] Pemeriksaan Laboratorium pada Thalassemia](/content/images/uploads/2022/09/cover-web-scaled.jpg)